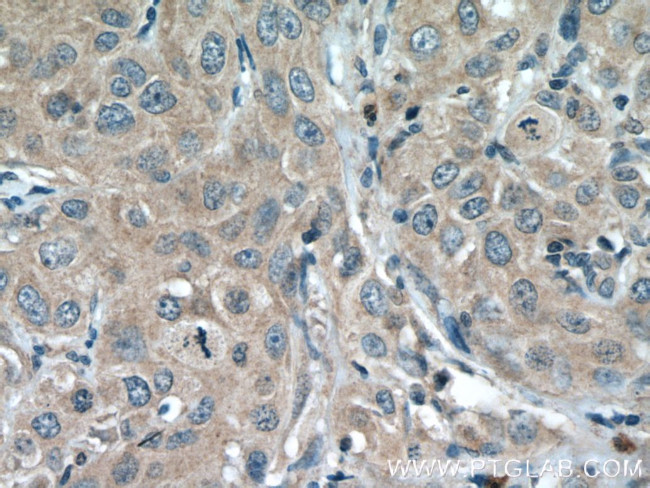
JAK1 Antibody in Immunohistochemistry (Paraffin) (IHC (P))

Search
Proteintech
JAK1 Monoclonal Antibody (3H7A8)
{{$productOrderCtrl.translations['antibody.pdp.commerceCard.promotion.promotions']}}
{{$productOrderCtrl.translations['antibody.pdp.commerceCard.promotion.viewpromo']}}
{{$productOrderCtrl.translations['antibody.pdp.commerceCard.promotion.promocode']}}: {{promo.promoCode}} {{promo.promoTitle}} {{promo.promoDescription}}. {{$productOrderCtrl.translations['antibody.pdp.commerceCard.promotion.learnmore']}}
产品信息
66466-1-IG
种属反应
已发表种属
宿主/亚型
分类
类型
克隆号
抗原
偶联物
形式
浓度
规格
纯化类型
保存液
内含物
保存条件
运输条件
产品详细信息
Immunogen sequence: EDCNAMAFC AKMRSSKKTE VNLEAPEPGV EVIFYLSDRE PLRLGSGEYT AEELCIRAAQ ACRISPLCHN LFALYDENTK LWYAPNRTIT VDDKMSLRLH YRMRFYFTNW HGTNDNEQSV WRHSPKKQKN GYEKKKIPDA TPLLDASSLE YLFAQGQYDL VKCLAPIRDP KTEQDGHDIE NECLGMAVLA ISHYAMMKKM QLPELPKDIS YKRYIPETLN KSIRQRNLLT RMRINNVFKD FLKEFNNKTI CDSSVSTHDL KVKYLATLET LTKHYGAEIF ETSMLLISSE NEMNWFHSND GGNVLYYEVM VTGNLGIQWR HKPNVVSVEK EKNKLKRKKL ENKHKKDEEK NKIREEW (8-363 aa encoded by BC132729)
靶标信息
Janus kinase 1 (JAK1), is a protein tyrosine kinase that is involved in the interferon-alpha/beta and -gamma signal transduction pathways. Immunological stimuli, such as interferons and cytokines, induce recruitment of Stat transcription factors to cytokine receptor-associated JAK1. JAK1 then phosphorylates proximal Stat factors, which subsequently dimerize, translocate to the nucleus and bind to cis elements upstream of target gene promoters to regulate transcription. Upon ligand binding, JAK1 undergoes tyrosine phosphorylation and catalytic activation in an interdependent manner. Phosphorylation of tyrosine residues at positions 1022 and 1023 is believed to function in the activation of catalytic events.
仅用于科研。不用于诊断过程。未经明确授权不得转售。
生物信息学
蛋白别名: EC 2.7.10.2; JAK-1; Janus kinase 1; Janus protein tyrosine kinase 1; kinase Jak1; Tyrosine-protein kinase JAK1
基因别名: AA960307; AIIDE; BAP004; C130039L05Rik; JAK1; JAK1A; JAK1B; JTK3
UniProt ID: (Human) P23458
Entrez Gene ID: (Human) 3716, (Rat) 84598, (Mouse) 16451